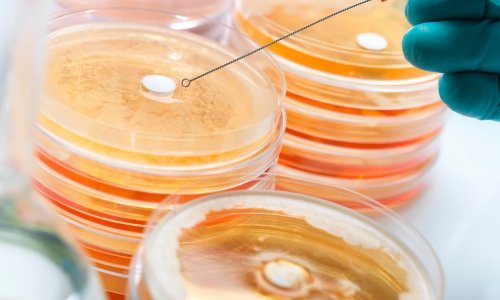
Ruđerovci otkrili 'sebične' bakterije u hrvatskim jezerima

Tim američkih znanstvenika tvrdi da je u eksperimentu otkrio novu boju, nazvanu ‘olo’, koju nijedno ljudsko biće dosad nije moglo prirodno vidjeti. Iako je dio stručne zajednice skeptičan prema ovom otkriću, rezultati su objavljeni u prestižnom časopisu Science Advances i već izazivaju burne rasprave.
U eksperimentu koji su proveli istraživači sa Sveučilišta u Kaliforniji i Sveučilišta u Washingtonu, sudionicima su u oko usmjeravali laserske pulseve, ciljajući određene stanice u mrežnici. Točnije, stimulirali su isključivo M-čepiće – stanice koje su osjetljive na zelene valne duljine svjetlosti.
U normalnim uvjetima, stimulacija jedne vrste čepića gotovo uvijek izaziva i djelomičnu stimulaciju susjednih čepića, no u ovom je slučaju laser djelovao isključivo na jednu vrstu stanica, čime su znanstvenici stvorili potpuno novi vizualni doživljaj.
Prema tvrdnjama sudionika, boja koju su vidjeli bila je zasićenija i intenzivnija od bilo koje boje iz svakodnevnog života, a opisali su je kao plavo-zelenu nijansu. Novi ton nazvan je ‘olo’, a njegovo postojanje otvorilo je brojna pitanja o granicama ljudske percepcije.
Nevjerojatno, ali teško dokazivo
Jedan od pet sudionika eksperimenta, suautor studije prof. Ren Ng, rekao je za BBC Radio 4 da je olo „zasićeniji od bilo koje boje koju možete vidjeti u stvarnom svijetu“. „Recimo da cijeli život vidite samo pastelno rozu boju. I onda jednog dana vidite najsnažniju rozu ikad i netko vam kaže da je to nova boja koju zovemo crvena. Takav je osjećaj bio vidjeti olo“, objasnio je Ng.
Sudionici su pomoću posebnog uređaja, nazvanog Oz, prilagođavali nijanse boje dok nisu postigli ton koji su percipirali tijekom stimulacije. Oz je sofisticirani sustav ogledala, lasera i optičkih instrumenata posebno dizajniran za ovakva istraživanja.
Međutim, iako eksperiment predstavlja impresivan tehnološki pothvat, neki znanstvenici izražavaju sumnje u zaključke. Prof. John Barbur, stručnjak za vid sa sveučilišta City St George’s u Londonu, koji nije sudjelovao u istraživanju, naglašava da percepcija nove boje može biti stvar interpretacije.
Jesu li granice percepcije pomaknute?
Prema Barburu, stimulacija velikog broja L-čepića (onih osjetljivih na crvenu) može dovesti do viđenja duboke crvene nijanse, no promjene u intenzitetu i osjetljivosti nisu neuobičajene. Slično bi se moglo dogoditi i u ovom eksperimentu, pa ostaje otvoreno pitanje je li olo zaista nova boja ili samo nova varijanta poznatih tonova.
Bez obzira na skeptična mišljenja, autori studije vjeruju da bi ovo otkriće moglo imati širu primjenu, posebno u razvoju terapija za osobe koje pate od sljepoće na boje. „Olo je tehnički izuzetno teško vidljiv, no nadamo se da će daljnje istraživanje pomoći osobama koje imaju teškoća u razlikovanju određenih boja“, istaknuo je prof. Ng.
Daljnji koraci uključuju ponavljanje eksperimenta s većim brojem sudionika i dodatne provjere kako bi se isključile subjektivne interpretacije. Također, znanstvenici će pokušati razviti metode koje bi omogućile da se novo otkrivena nijansa vidi i bez invazivne laserske stimulacije.